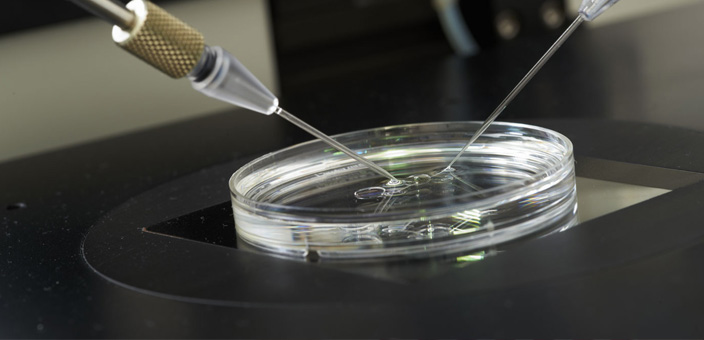

“Medicina ed etica non viaggiano alla stessa velocità: la prima varca continuamente nuove frontiere, la seconda chiede tempo per esaminare i nuovi scenari ed esprimere le proprie valutazioni”.
Questa interessante riflessione, è del Professor Giuseppe Remuzzi, che il 28 novembre alle ore 21.00 nella Biblioteca di Brugherio, terrà un incontro all’interno della rassegna “Scienza Ultima Frontiera”.
“Forzare il limite? Medicina di domani- Etica di ieri“. Verterà intorno a questo la serata condotta da Remuzzi, Ricercatore con un curriculum di immenso spessore.
Direttore del Dipartimento d’Immunologia e Clinica dei Trapianti di Organi dell’Istituto Mario Negri di Bergamo, Direttore dell’U.O. di Nefrologia e Dialisi, e Direttore del Dipartimento di Medicina dell’A.O. Papa Giovanni XXIII di Bergamo, il Professor Remuzzi accompagnerà il pubblico in un’intesa discussione che toccherà più argomenti: dai trapianti di organi, con il divario immenso tra numero di pazienti in attesa di trapianto e disponibilità, sino a questioni legate al progresso medico, all’etica, ai criteri che segnano le linee guida di un pensiero etico, per poi arrivare a riflettere sui comitati di bioetica e su questioni delicate come il testamento biologico.
“La medicina è autorizzata a varcare ogni confine in nome di un progresso ad ogni costo? -continua la riflessione del Dottor Remuzzi– Chi può stabilire dove fermarsi? Da dove ci arrivano i criteri etici che tracciano il confine tra bene e male, tra consentito e proibito?.”
E’ facile capire come tutta al comunità sia toccata da questi argomenti e ragionamenti, e per tanto l’incontro gratuito è aperto a tutti, soprattutto a chi ha le idee più confuse, a chi non è esperto in materia e vuole farsi un’idea chiara.
Informazioni sono disponibili telefonando al numero 039. 2893400/410, oppure scrivendo a: biblioteca@comune.brugherio.mb.it
KAROL MATTAREL